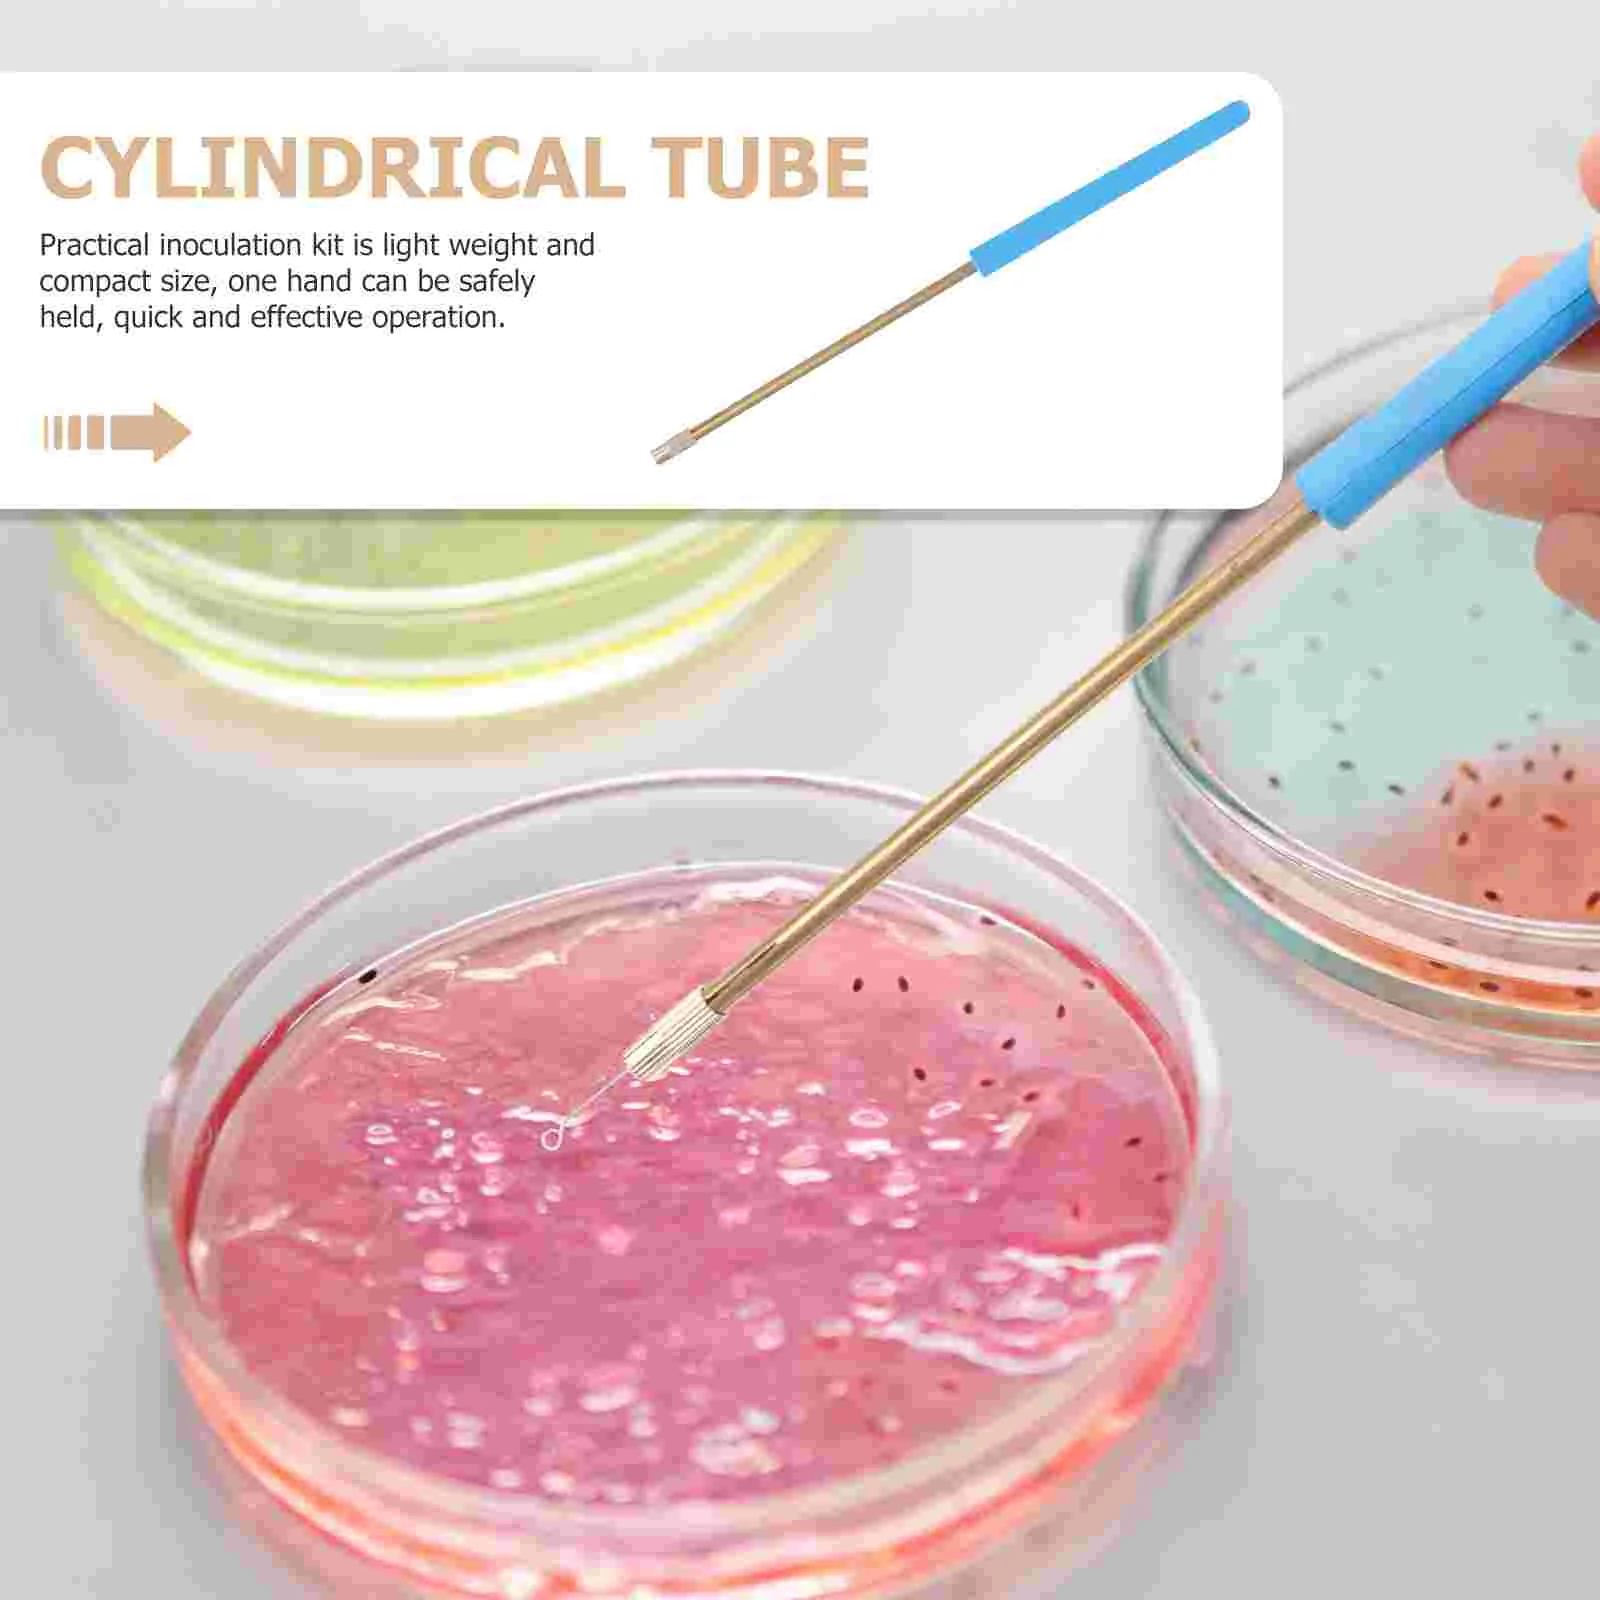
thumb

Inoculation Set Inoculation Kit Microbiology Inoculation Rings Kit Tool Microbiology Inoculation Rods Inoculation Set
Price history chart & currency exchange rate
Customers also viewed

$42.30
INS Nordic Small Unit Fabric Art Modern Simple Single гостиная Velvet светильник роскошный ленивый диван дизайнерский тигровый стул
aliexpress.ru
$72.54
Мини-шприц для смазки велосипедов емкостью 80 куб. см, 1000 фунтов на кв. дюйм для смазки небольших аксессуаров
joom.com
$40.02
Удобный мужской спортивный кардиган с воротником-поло и длинными рукавами LCWAIKIKI Classic
cdek.shopping
$19.90
Just DON 2022 New Best York Pink Knick Basketball Shorts Los Good Angeles Blue Lakeres Memphi Grizzlie Charlottes Hornet Pocket Shorts Quick Dry, Just shorts
dhgate.com
$21.30
Новые потертые штаны для йоги с дырками, бесшовные, с высокой талией, спортивные брюки с девятью точками, брюки для фитнеса с эффектом бедер, ...
aliexpress.ru
$8.22
Женские Сумки из искусственной кожи, женская сумка через плечо, дизайнерская роскошная женская сумка-тоут, вместительная сумка через плечо ...
aliexpress.ru
$5.36
factory outlet christmas decoration decorations 80mm tree ball baubles xmas party wedding hanging ornament christmas decoration supplies sqz
dhgate.com
$37.79
Противотуманная машина, портативная дымовая машина 500 Вт для Хэллоуина с цветными светодиодными фонарями, пульт дистанционного управления,...
aliexpress.ru
$20.96
AL0602A 7 дюймов высокого качества ЖК-дисплей Экран 00 AL0602A AL0801A ЖК-дисплей Панель ЖК-дисплей дисплей HD 164x97 мм 1024X600 Бесплатная доставка
aliexpress.ru
$118.92
boots boots leather flat bottomed short riveted chelsea single british martin, Black
dhgate.com
$12.24
Slithice Life is too short to make others shorter Hipster Sweatshirts Women Cotton hoodie Letter Print Sweatshirt sudadera mujer
aliexpress.com
$33.39
Стул для кухни, кафе, бара, ресторана Веста дерево бук/пластик, кожзам белый Woody
rozetka.com.ua
$13.48
Сорочка Anabel Arto 42() сиреневый горошек, Сорочка Anabel Arto 42(S) сиреневый горошек
rozetka.com.ua
$1.76
Cool Japan JDM Sports Car Comic Phone Case Transparent for iPhone Samsung A S 11 12 6 7 8 9 10 20 Pro X XS Max XR Plus lite
aliexpress.com
$36.15
New Arrival Seamless Woman Yoga Set High Elastic Padded Shock Proof Sports Bralette High Waist Stretchy Hips Up Tight Activewear
aliexpress.com
$3.69
Shockproof Soft Case For Huawei Y7a Y7p Y9 2019 Prime Y7 Pro Y6 Y5 2018 Phone Case Cover
aliexpress.com
$39.62
Женские юбки-карандаш, винтажные юбки с цветами для девочек, Женская мини-юбка в стиле "Лолита"
aliexpress.ru
$17.61
Многофункциональный универсальный держатель для камеры, подставка для монитора, крепление на кровать, регулируемый длинный кронштейн
aliexpress.ru
$44.26
paintings chenistory coloring by numbers flowers handpainted cat animal for childern drawing canvas kits diy home decoration gift
dhgate.com
$5.77
1Pc Portable Garden Digging Tool Mini Shovel For Home Garden Transplanting Tool W0YD
aliexpress.com
$58.50
Silk Nightdress Summer Sexy Lace Thin Mulberry Silk Suspender Skirt Pure Silk Pajamas
aliexpress.com
$16.99
Creative Ceramic Aromatherapy Furnace Purple Clay Pottery Incense Burner Backflow Incense Holder Clear Cover Craft Incense Base
aliexpress.com
$12.76
1PC Cartoon Animal Style Waterproof Kids Raincoat For Children Rain Coat Rainwear/Rainsuit Student Poncho Fast delivery
aliexpress.com
$0.57
New Elastic Locking Shoelaces Kids Adult Sneakers Lazy Shoe Laces No Tie Flat Locking Shoelaces Magnetic Shoes Strings 1 Pairs
aliexpress.com
$4.50
NEW Remote Control 433MHZ Clone Fixed Learning Code For Gate Cloning Door Fob Key A Distance Control Remote Garage Duplic W1U3
aliexpress.com
$85.17
Pureturn 28 Окрашивающий крем Отбеливающий отбеливающий пигментный эксклюзивный крем, 1 шт.
joom.com
$177.27
ZAPPO LED Rain Shower Fixtures Thermostatic Multiple Shower System with Body Jets Ceiling Mounted Brass Shower Faucet Combo Set
aliexpress.com
$22.29
Юбка на бретельках для питомцев в ковбойском стиле, штаны для кошек и четвероногих, милый комплект для пары питомцев, пижама для собак, одежда для щенков, комбинезон для собак L
joom.com
$55.15
Картофельная давилка Силиконовый Чеснокодавка из нержавеющей стали Bald Machine Чеснокодавка Безопасная кухонная помощь Картофельная давилка Stanless серебряный
joom.com
$48.12
Тени для век в карандаше, сияющие как трехцветная градиентная звезда, 04#Glitter Orange Coffee*2
joom.com
$7.79
Футболка для гольфа, высокая стабильность, низкое трение, износостойкая, съемная, простая установка, короткая футболка для гольфа, тренировочный инструмент красный
joom.com
$6.74
4/8 шт., зажимы для шитья, зажимы для подшивки ткани из нержавеющей стали, аксессуары для маркировки ткани, принадлежности для квилтинга 4pcs
joom.com
$12.87
Ювелирные серьги ручной работы с драгоценным камнем лазурит 925 пробы, посеребренные, 1,89 дюйма
joom.com